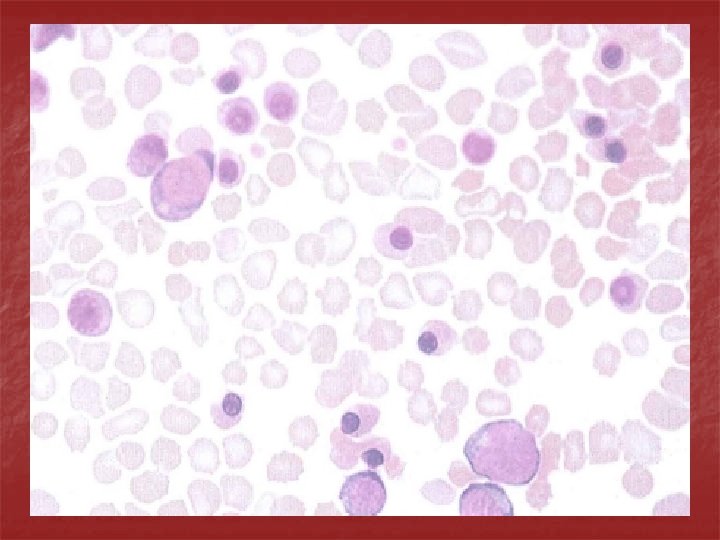
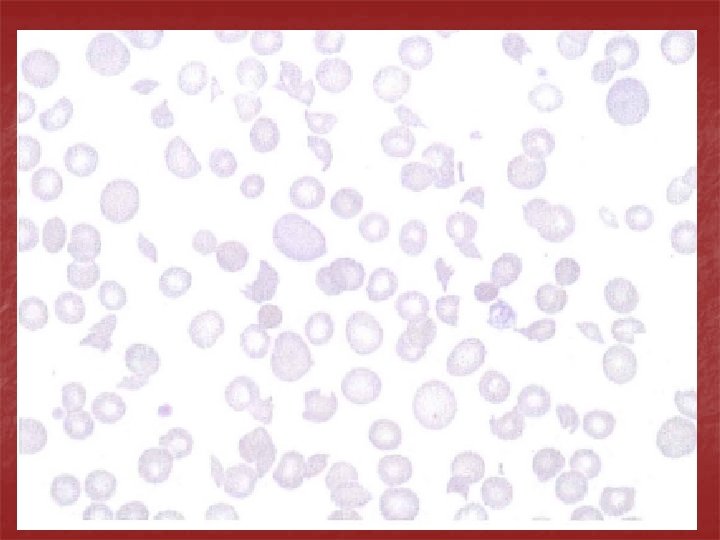

Acquired Hemolytic Anemias Immune Hemolytic Anemias n n

- Slides: 31
Acquired Hemolytic Anemias
Immune Hemolytic Anemias n n Antibody mediated hemolysis is an important cause of acquired hemolytic anemia. Antibodies may be autoantibodies produced by the patiet’s own immune system & directed against his own red cell antigens, or they may be alloantibodies produced by the patient & directed against antigens not present on his own red cells but introduced either by transfusion or secondarily acquired as in drug induced hemolysis. The immune hemolytic anemias are characterized by a positive direct Coomb’s test.
Autoimmune Hemolytic Anemias
n n Warm autoimmune hemolytic anemia: The autoantibodies are polyclonal & Ig. G in type. They react best at 37 o. C. Red cells coated with Ig. G are taken up by macrophages especially in the spleen which have receptors for the Fc fragment. Part of the coated membrane is lost so the cell becomes progreesively more spherical to maintain its volume & is ultimately prematurely destroyed predominantly in the spleen.
n n n Clinical features: the disease can occur at any age in both sexes & presents as a hemolytic anemia of variable severity. The spleen is often enlarged. It is classified as: Idiopathic Secondary to autoimmune disoders, lymphoma, CLL, drugs
Laboratory findings: n n Features of hemolytic anemia: anemia, reticulocytosis, jaundice. Direct Coomb’s test is positive. Blood film shows spherocytes, polychromasia & nucleated red cells.
Cold autoimmune hemolytic anemia: n The cold autoantibody attaches to red cells mainly in the peripheral circulation where blood temperature is cooled. The antibody is usually Ig. M & binds to red cells best at 4 o. C. Agglutination of red cells by the antibody causes acrocyanosis. The antibody then detaches from red cells when they pass to the warmer central circulation & if the complement sequence is completed on the red cell surface; intravascular hemolysis will result.
Etiology: types of cold autoimmune hemolytic anemia are: n Idiopathic (cold hemagglutinin disease): monoclonal antibody. n Secondary to lymphoproliferative disease: monoclonal antibody. n Secondary to infection (Mycoplasma pneumoniae or infectious mononucleosis): polyclonal antibody.
n Clinical features: the patient may have chronic hemolytic anemia aggravated by cold & often associated with intravascular hemolysis. The patient may develop acrocyanosis (purplish skin discoloration) at the tip of the nose, ears, fingers & toes due to the agglutination of red cells in small vessels. Mild jaundice & splenomegaly may be present.
Laboratory findings: n Features of hemolytic anemia. n Direct Coomb’s test is positive. n Blood film shows red cell autoagglutination.
Alloimmune Hemolytic Anemias
Rh Hemolytic disease of the newborn: n This results from passage of Ig. G antibodies from the maternal circulation across the placenta into fetal circulation where they react with fetal red cells & mediate destruction by fetal reticuloendothelial system.
In Rh D negative woman pregnant with an Rh D positive fetus, when fetal red cells cross into the maternal circulation (usually at delivery) they will sensitize the mother to produce anti-D antibodies. The mother could also be sensitized by a previous miscarriage, amniocentesis or other trauma to the placenta or by blood transfusion. Anti-D antibodies will cross the placenta to the fetus during the next pregnancy with a D-positive fetus, coat fetal red cells & result in their destruction causing anemia & jaundice.
n Clinical features: n The severity is variable. In severe disease: intrauterine death results from hydrops fetalis. In moderate disease; the baby is born with severe anemia, jaundice, edema & hepatosplenomegaly. Kernicterus may result.
Laboratory findings: n n Cord blood: there is variable anemia, reticulocytosis & jaundice. The baby is Rh positive. Direct Coomb’s test is positive. In moderate & severe cases many erythroblasts are seen in the blood film (erythroblastosis fetalis). The mother is Rh D negative & has a high level of anti-D.
Non Immune Hemolytic Anemias
Red cell fragmentation syndromes: These arise through physical damage to red cells either on n abnormal sufaces (e. g. artificial heart valves) or n microangiopathic hemolytic anemia caused by red cells passing through fibrin strands deposited in small vessels due to DIC or n passing through damaged small vessels in malignant hypertension, the hemolytic uremic syndrome or meningococcal sepsis. n Blood film shows many red cell fragments.
Aplastic Anemia n Aplastic anemia is defined as pancytopenia (anemia+ leucopenia+ thrombocytopenia) resulting from aplasia of the bone marrow.
Etiology: n n Primary: Congenital e. g. Fanconi’s anemia Idiopathic Secondary: to one of the following n Ionizing radiation n Chemicals: benzene & other organic solvents, insecticides, hair dyes n Drugs: Which regularly cause marrow depression e. g. busulphan, cyclophosphamide. Which rarely cause marrow depression e. g. chloramphenicol, sulphonamides. n Infection: viral hepatitis (non-A non-B)
n Pathogenesis: the underlying defect in all cases appears to be a substantial reduction in the number of stem cells & a fault in the remaining stem cells or an immune reaction against them. This makes them unable to divide & differentiate sufficiently to populate the bone marrow. A primary fault in the marrow microenvironment has also been suggested but the success of bone marrow transplantation shows this can only be a rare cause since normal donor stem cells are usually able to thrive in the recipient’s marrow cavity.
n n n Clinical features: The onset is at any age with a peak incidence around 30 years & a slight male predominance. It can be insidious or acute with symptoms & signs resulting from anemia, neutropenia or thrombocytopenia. Infections, particularly of the mouth & throat, are common. Generalized infections are frequently life threatening. Bruising, bleeding gums, epistaxes & menorragia are the most frequent hemorrhagic manifestations & the usual presenting features. Symptoms of anemia. The lymph nodes, liver& spleen are not enlarged.
n Laboratory findings: n n Anemia is normochromic normocytic or macrocytic. The retic count is reduced. Leucopenia. There is selective neutropenia usually but not always to below 1. 5 x 109/L. The neutrophils appear normal. Thrombocytopenia is always present & in severe cases is less than 10 x 109/L. There are no abnormal cells in the peripheral blood.
n Bone marrow shows hypoplasia with loss of hemopoietic tissue & replacement by fat. Bone marrow biopsy is essential & may show patchy cellular areas in a hypocellular background. The main cells present are lymphocytes & plasma cells.
Differential diagnosis: Other causes of pancytopenia are: n n Bone marrow infiltration e. g. carcinoma, lymphoma. n Leukemia, MDS, myeloma. n Hypersplenism. n Megaloblastic n Myelofibrosis. anemia.